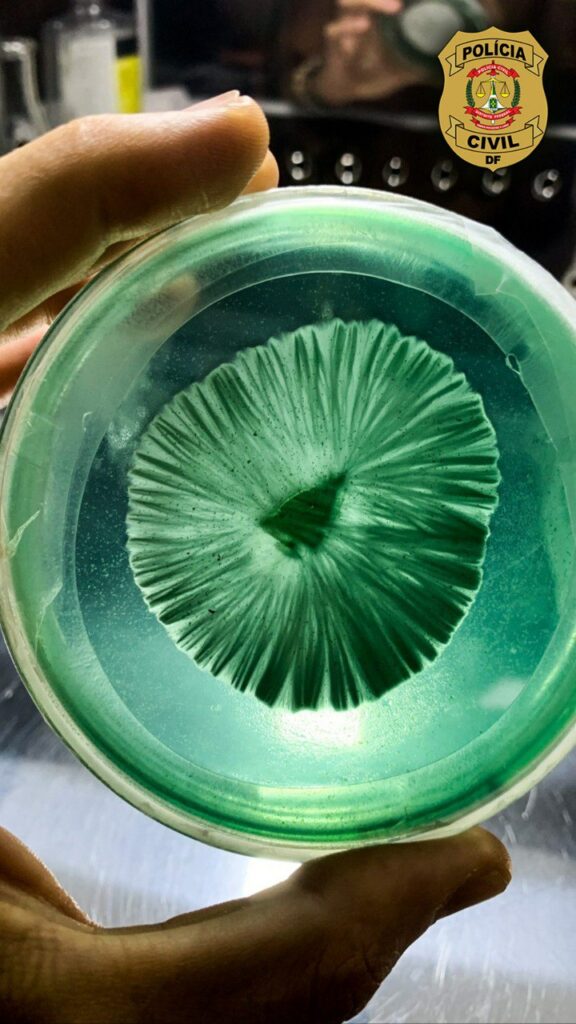
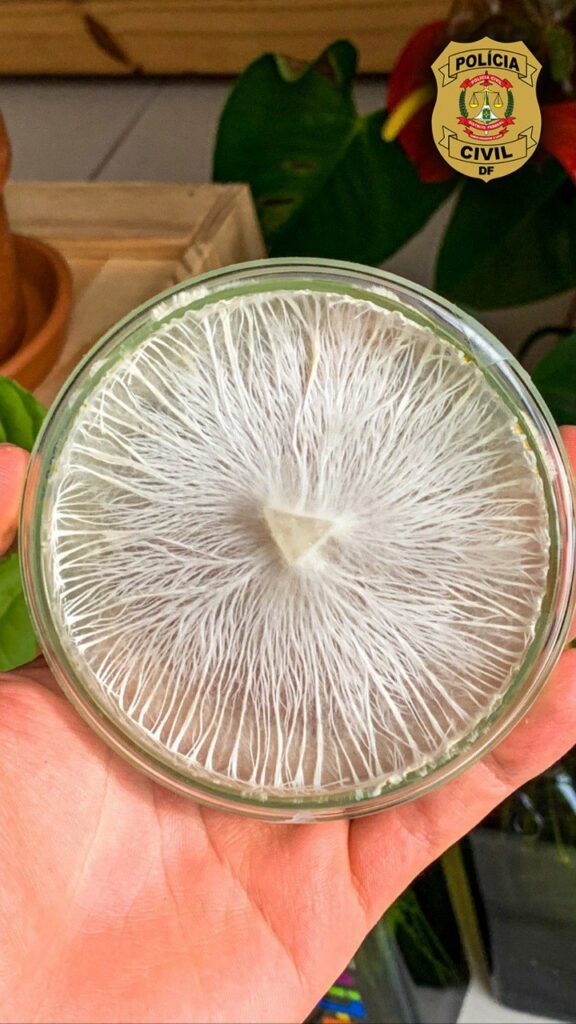

A Polícia Civil do Distrito Federal (PCDF) prendeu, nesta quarta-feira (26), um homem de 29 anos, acusado de administrar um laboratório clandestino para produção de cogumelos alucinógenos e substâncias derivadas em um apartamento de alto padrão localizado no Lago Norte.
Segundo as investigações que culminaram na Operação Cogumelo Mágico e duraram cinco meses, período em que os policiais acompanharam a venda das drogas pela internet, o suspeito estudou neurociência na Austrália e cursou quatro anos de medicina na Argentina. O próprio realizava a comercialização dos cogumelos por meio de uma estrutura on-line que ele criou para a venda em larga escala para todo o Brasil e exterior.
Ainda de acordo com a Coordenação de Repressão às Drogas (CORD) da PCDF, no site, o autor oferecia uma “calculadora”, que calculava a dosagem adequada da substância a ser utilizada por cada comprador, além de exibir comentários, com uma espécies de “feedbacks” que teriam sido escritos por de clientes. Com o apoio da Delegacia de Repressão às Drogas (DRCC), o site no qual eram vendidas essas substâncias foi retirado do ar.
“O que chama atenção da CORD neste caso, e que serve de alerta à população de todo o DF, é que ele se utilizava de ‘fake news’, nos sites e nas redes sociais, dizendo que esses cogumelos eram naturais e por isso tinham seu uso liberado em todo território nacional”, afirma o delegado chefe da CORD, Rogério Henrique de Oliveira.
Durante as buscas no laboratório os policiais encontraram, além equipamentos modernos próprios da indústria farmacêutica, estufa e rotina de envase e distribuição, produtos perigosos que poderiam causar um acidente de grandes proporções. No local, foram apreendidas milhares de cápsulas e litros de produtos ilícitos, extratos vegetais e vários quilos de cogumelos in natura.
Entre os cogumelos apreendidos, segundo a polícia, estão aqueles que possuem o alcaloide psilocibina, uma substância altamente viciante e que causa graves danos à saúde física e mental. Eram vendidos tanto na forma “in natura” quanto processados, envazados em compridos e em tintura (para serem utilizado como “florais”). As drogas, segundo as investigações, eram enviadas aos compradores através de serviços de entrega que não tinham conhecimento do teor ilícito do que estaria sendo transportado.

O preso foi indiciado pelos crimes de tráfico de drogas, venda de substâncias e coisas nocivas à saúde, exercício ilegal da medicina, curandeirismo e incitação ao crime. Somadas as penas podem chegar a 33 anos de reclusão, caso seja condenado.





